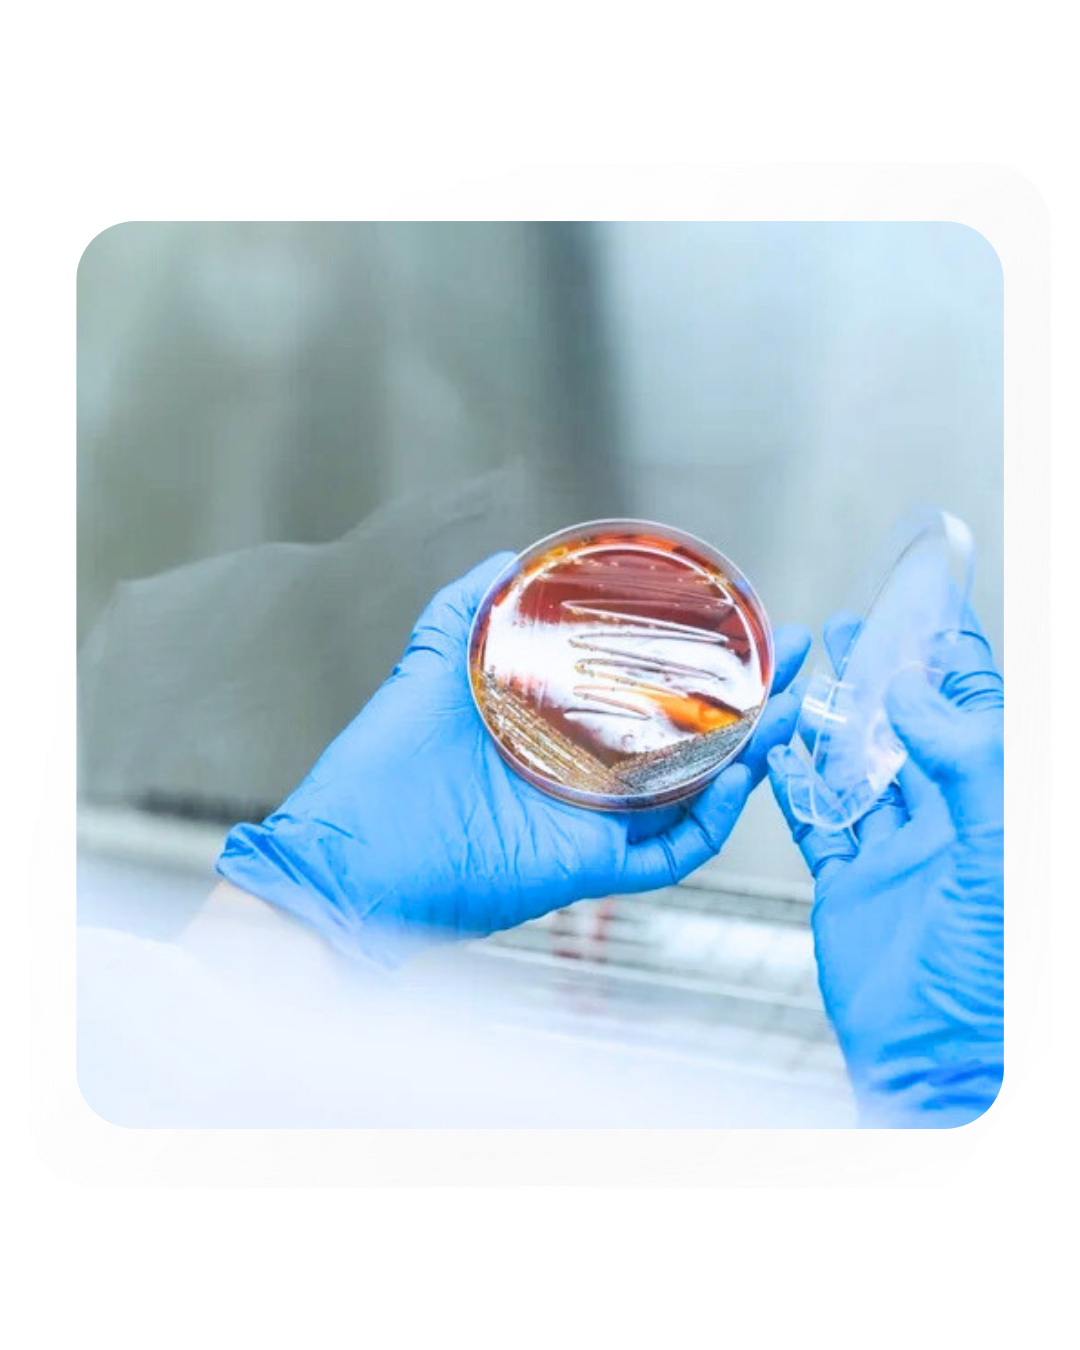

SHT’s Full Panel Lab Test and Services for herbs and products
At SHT, we provide a full panel service for lab test with complete certifications of GMP PIC/S, ISO17025, and EU GMP (processing). We have full suite of equipments to perform cannabinoid efficacy tests, alkaloid efficacy tests, terpene tests, microbial tests, heavy metal tests, and others. In addition, we also provide a full certified stability test in our base stability chamber and accelerated stability chamber.
Furthermore, we are also providing full panel tests for kratom, and kratom extracted compounds such as mitragynine, and 7 hydroxy mitragynine. Please contact us for further information @ +6634-119-775

ISO17025 Lab Testing Services

Cannabis Flowers Lab Test Services


Service Brochure (click on image to download PDF file)


